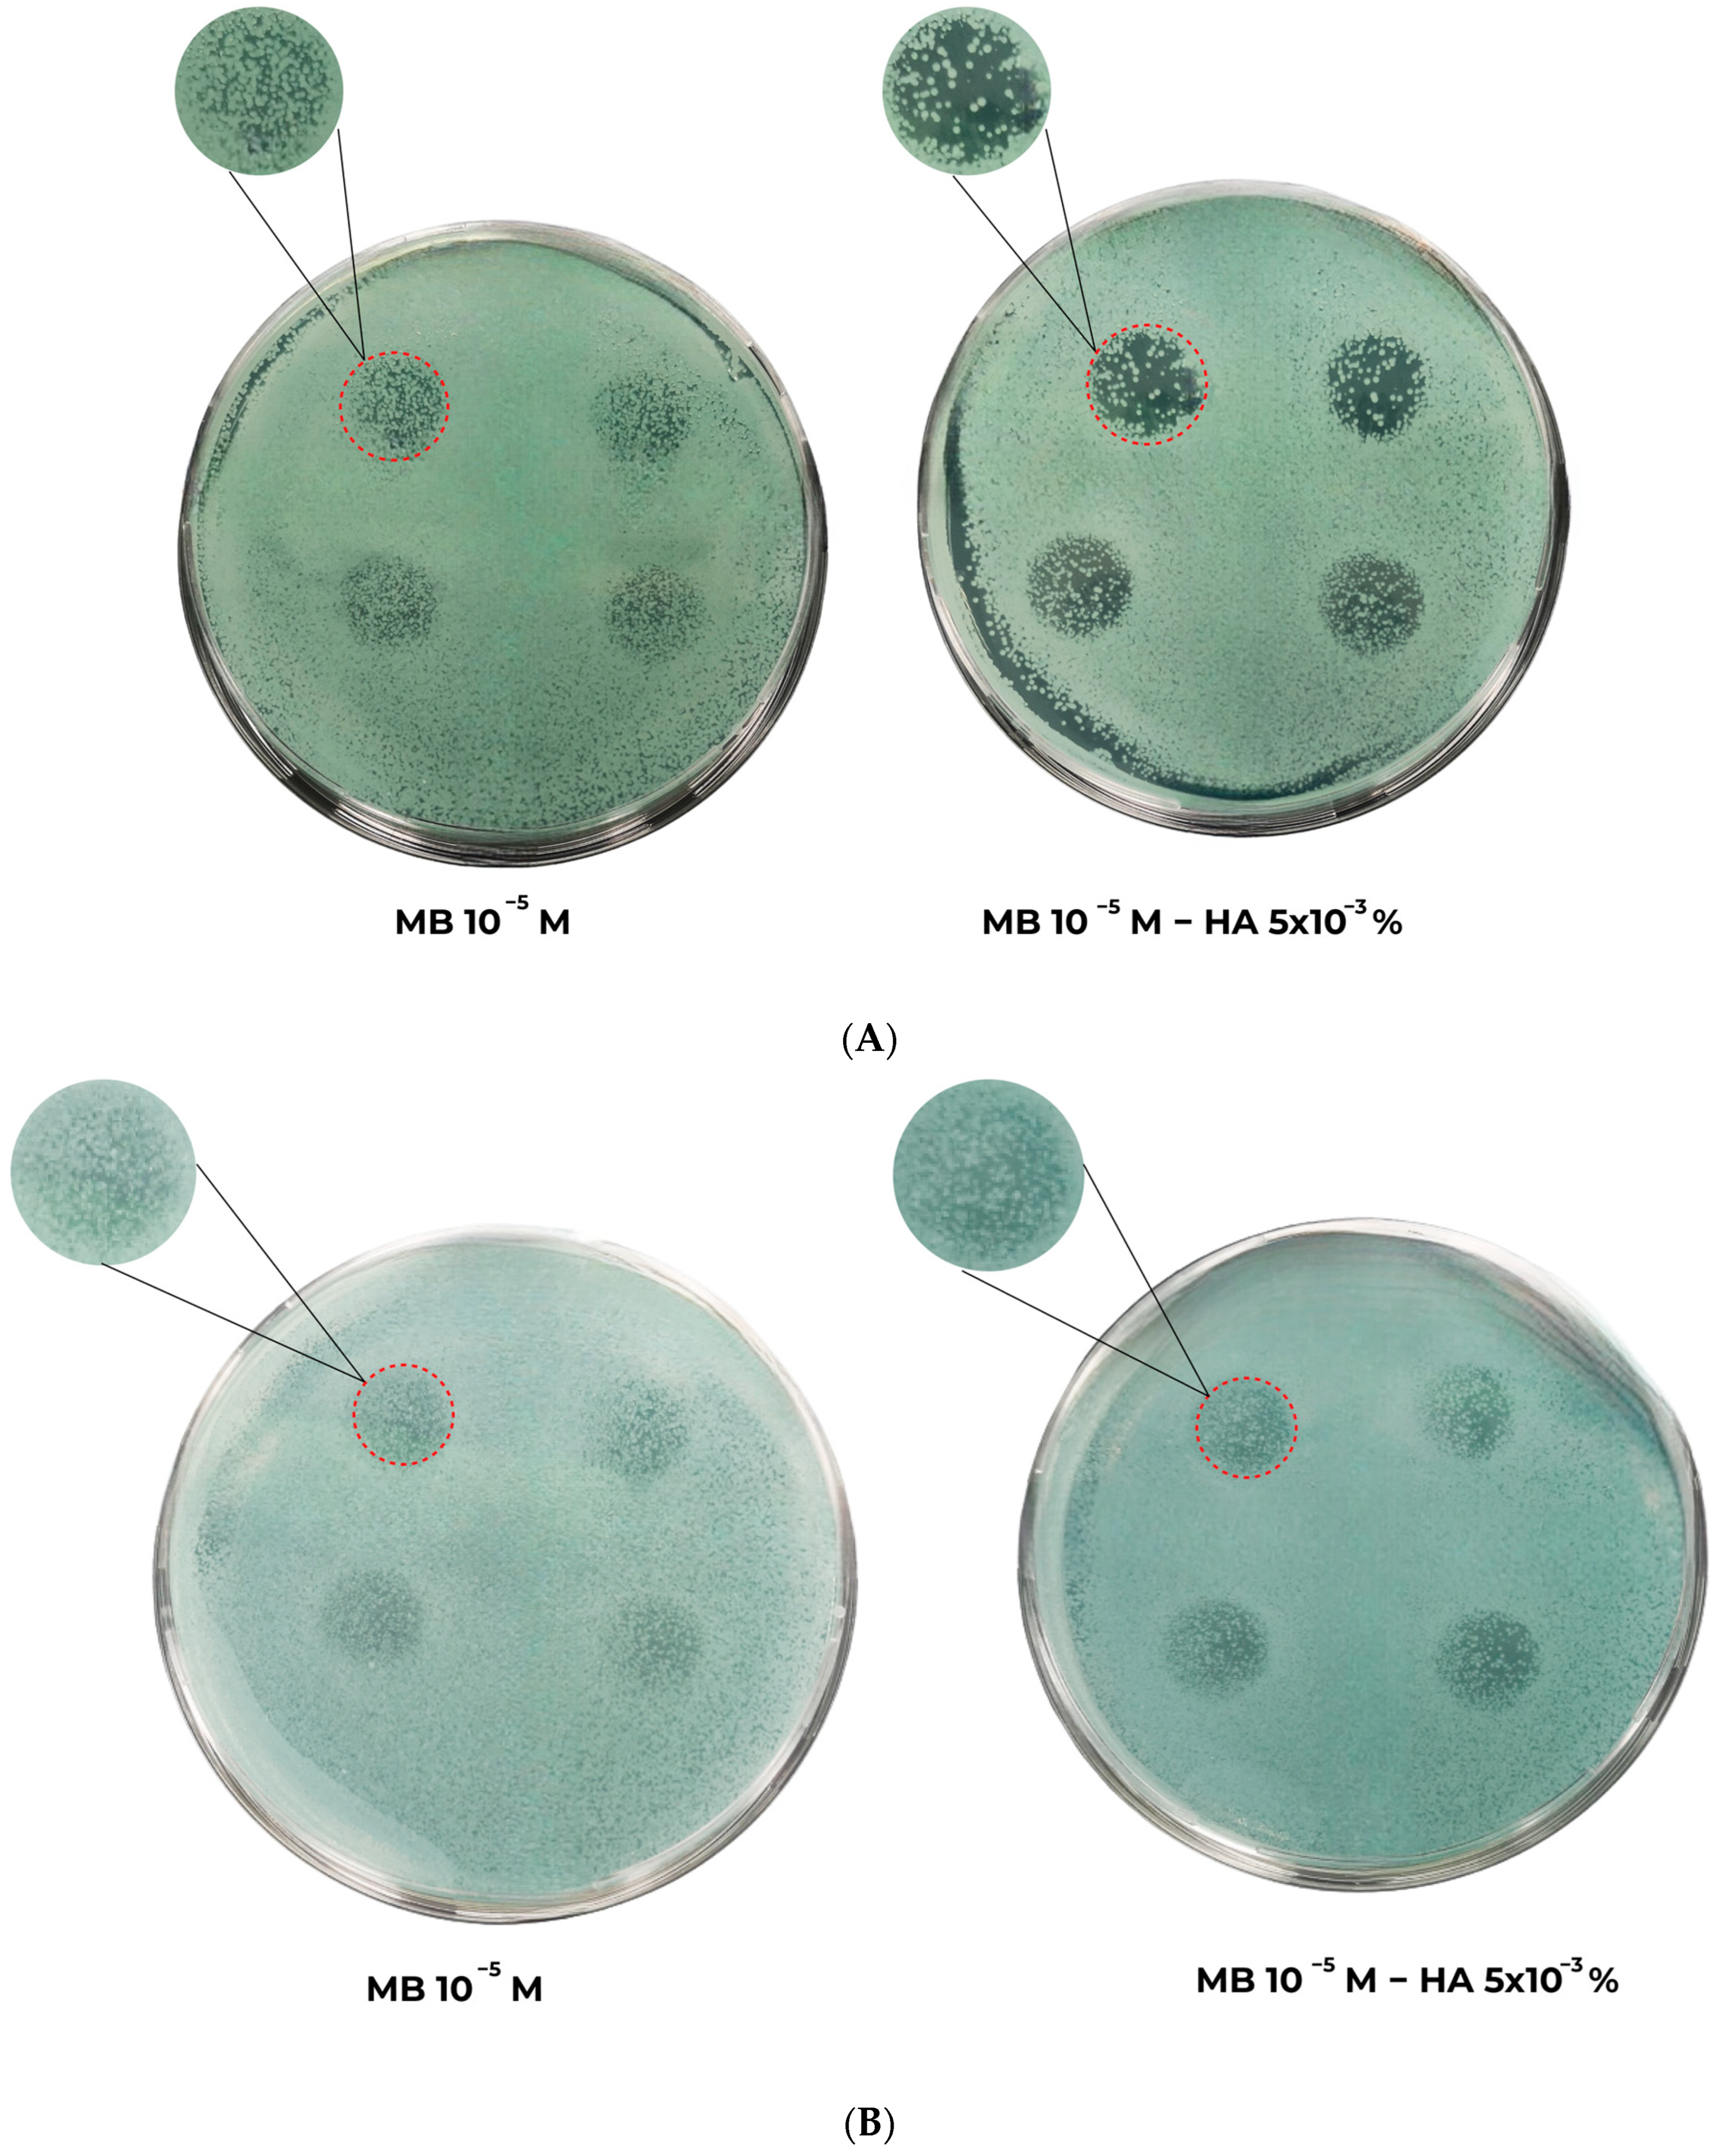

Effect of Hyaluronic Acid on the Activity of Methylene Blue in Photogeneration of 1O2
Abstract
1. Introduction
2. Results and Discussion
2.1. Electronic Absorption Spectra of MB and MB-HA
2.2. Fluorescence Anisotropy
2.3. 1H-NMR
2.4. FT-IR
2.5. Photodynamic Activity of MB and MB-HA
3. Materials and Methods
3.1. Reagents
3.2. Preparation of the MB-HA System and Study of Its Photosensitizing Properties in the Generation of Singlet Oxygen
3.3. Spectral Research
3.4. Photodynamic Activity of MB and MB-HA
4. Conclusions
Author Contributions
Funding
Institutional Review Board Statement
Informed Consent Statement
Data Availability Statement
Conflicts of Interest
References
- Salam, A.; Al-Amin, Y.; Salam, M.T.; Pawar, J.S.; Akhter, N.; Rabaan, A.A.; Alqumber, M.A.A. Antimicrobial Resistance: A Growing Serious Threat for Global Public Health. Healthcare 2023, 11, 1946. [Google Scholar] [CrossRef]
- WHO. Ten Threats to Global Health in 2019. Available online: https://www.who.int/news-room/spotlight/ten-threats-to-global-health-in-2019 (accessed on 9 March 2022).
- Antimicrobial Resistance Collaborators. Global burden of bacterial antimicrobial resistance in 2019: A systematic analysis. Lancet 2022, 399, 629–655. [Google Scholar] [CrossRef]
- Sun, Y.; Ogawa, R.; Xiao, B.; Feng, Y.; Wu, Y.; Chen, L.; Gao, X.; Chen, H. Antimicrobial Photodynamic Therapy in Skin Wound Healing: A Systematic Review of Animal Studies. Int. Wound J. 2020, 17, 285–299. [Google Scholar] [CrossRef]
- Torabi, S.; Joharchi, K.; Kalhori, K.A.M.; Sohrabi, M.; Fekrazad, R. Evaluation of Antimicrobial Photodynamic Therapy on Wounds Infected by Staphylococcus aureus in Animal Models. Photodiagnosis Photodyn. Ther. 2021, 33, 102092. [Google Scholar] [CrossRef]
- Dharmaratne, P.; Sapugahawatte, D.N.; Wang, B.; Chan, C.L.; Lau, K.-M.; Lau, C.B.; Fung, K.P.; Ng, D.K.; Ip, M. Contemporary Approaches and Future Perspectives of Antibacterial Photodynamic Therapy (aPDT) against Methicillin-Resistant Staphylococcus aureus (MRSA): A Systematic Review. Eur. J. Med. Chem. 2020, 200, 112341. [Google Scholar] [CrossRef]
- Sharma, S.K.; Mroz, P.; Dai, T.; Huang, Y.; St. Denis, T.G.; Hamblin, M.R. Photodynamic Therapy for Cancer and for Infections: What Is the Difference? Isr. J. Chem. 2012, 52, 691–705. [Google Scholar] [CrossRef]
- Klausen, M.; Ucuncu, M.; Bradley, M. Design of Photosensitizing Agents for Targeted Antimicrobial Photodynamic Therapy. Molecules 2020, 25, 5239. [Google Scholar] [CrossRef]
- Huang, Y.-Y.; Sharma, S.K.; Dai, T.; Chung, H.; Yaroslavsky, A.; Garcia-Diaz, M.; Chang, J.; Chiang, L.Y.; Hamblin, M.R. Can Nanotechnology Potentiate Photodynamic Therapy? Nanotechnol. Rev. 2012, 1, 111–146. [Google Scholar] [CrossRef]
- Meerovich, G.A.; Akhlyustina, E.V.; Tiganova, I.G.; Lukyanets, E.A.; Makarova, E.A.; Tolordava, E.R.; Yuzhakova, O.A.; Romanishkin, I.D.; Philipova, N.I.; Zhizhimova, Y.S.; et al. Novel Polycationic Photosensitizers for Antibacterial Photodynamic Therapy. In Book Advances in Microbiology, Infectious Diseases and Public Health; Donelli, G., Ed.; Microbial Biofilm Laboratory Fondazione Santa Lucia IRCCS: Rome, Italy, 2019; Volume 14, pp. 1–14. [Google Scholar]
- Hamblin, M.R.; Hasan, T. Photodynamic Therapy: A New Antimicrobial Approach to Infectious Disease? Photochem. Photobiol. Sci. 2004, 3, 436–450. [Google Scholar] [CrossRef]
- Fernández-Pérez, A.; Marban, G. Visible Light Spectroscopic Analysis of Methylene Blue in Water; What Comes after Dimer? ASC Omega 2020, 5, 29801–29815. [Google Scholar] [CrossRef]
- Morgounova, E.; Shao, Q.; Hackel, B.J.; Thomas, D.D.; Ashkenazi, S. Photoacoustic Lifetime Contrast between Methylene Blue Monomers and Self-Quenched Dimers as a Model for Dual-Labeled Activatable Probes. J. Biomed. Opt. 2013, 18, 056004. [Google Scholar] [CrossRef] [PubMed]
- Alasqah, M.N. Efficacy of Methylene Blue-Mediated Antimicrobial Photodynamic Therapy on Clinical and Radiographic Outcomes among Patients with Periodontal Diseases: A Systematic Review and Meta-Analysis of Randomized Controlled Trials. Photodiagnosis Photodyn. Ther. 2024, 46, 104000. [Google Scholar] [CrossRef] [PubMed]
- Figueiredo Souza, L.W.; Souza, S.V.T.; Botelho, A.C.C. Randomized Controlled Trial Comparing Photodynamic Therapy Based on Methylene Blue Dye and Fluconazole for Toenail Onychomycosis: Trial Photodynamic Therapy Onychomycosis. Dermatol. Ther. 2014, 27, 43–47. [Google Scholar] [CrossRef] [PubMed]
- De Santi, M.E.S.O.; Prates, R.A.; França, C.M.; Lopes, R.G.; Sousa, A.S.; Ferreira, L.R.; Bussadori, S.K.; Fernandes, A.U.; Deana, A.M. Antimicrobial Photodynamic Therapy as a New Approach for the Treatment of Vulvovaginal Candidiasis: Preliminary Results. Lasers Med. Sci. 2018, 33, 1925–1931. [Google Scholar] [CrossRef]
- Vallejo, M.C.S.; Moura, N.M.M.; Gomes, A.T.P.C.; Joaquinito, A.S.M.; Faustino, M.A.F.; Almeida, A.; Gonçalves, I.; Serra, V.V.; Neves, M.G.P.M.S. The Role of Porphyrinoid Photosensitizers for Skin Wound Healing. Int. J. Mol. Sci. 2021, 22, 4121. [Google Scholar] [CrossRef]
- Tong, A.; Tong, C.; Fan, J.; Shen, J.; Yin, C.; Wu, Z.; Zhang, J.; Liu, B. Prussian Blue Nano-Enzyme-Assisted Photodynamic Therapy Effectively Eradicates MRSA Infection in Diabetic Mouse Skin Wounds. Biomater. Sci. 2023, 11, 6342–6356. [Google Scholar] [CrossRef]
- Liu, S.; Feng, Y.; Tan, Y.; Chen, J.; Yang, T.; Wang, X.; Li, L.; Wang, F.; Liang, H.; Zhong, J.; et al. Photosensitizer-loaded Hydrogels: A New Antibacterial Dressing. Wound Repair Regen. 2024, 32, 301–313. [Google Scholar] [CrossRef]
- Graça, M.F.P.; Miguel, S.P.; Cabral, C.S.D.; Correia, I.J. Hyaluronic Acid—Based Wound Dressings: A Review. Carbohydr. Polym. 2020, 241, 116364. [Google Scholar] [CrossRef] [PubMed]
- Cortes, H.; Caballero-Florán, I.H.; Mendoza-Muñoz, N.; Córdova-Villanueva, E.N.; Escutia-Guadarrama, L.; Figueroa-González, G.; Reyes-Hernández, O.D.; González-Del Carmen, M.; Varela-Cardoso, M.; Magaña, J.J.; et al. Hyaluronic Acid in Wound Dressings. Cell Mol. Biol. 2020, 66, 191–198. [Google Scholar] [CrossRef]
- Kuryanova, A.S.; Kardumyan, V.V.; Kaplin, V.S.; Aksenova, N.A.; Chernyak, A.V.; Timofeeva, V.A.; Glagolev, N.N.; Timashev, P.S.; Solovieva, A.B. Effect of amphiphilic polymers and sodium alginate on the activity of methylene blue in photogeneration of singlet oxygen 1O2. Laser Phys. 2023, 33, 095601. [Google Scholar] [CrossRef]
- Mendes, B.; Kassumeh, S.; Aguirre-Soto, A.; Pei, Q.; Heyne, B.; Kochevar, I.E. Influence of Rose Bengal Dimerization on Photosensitization. Photochem. Photobiol. 2021, 97, 718–726. [Google Scholar] [CrossRef] [PubMed]
- Borisov, S.M.; Blinova, I.A.; Vasil’ev, V.V. The Influence of Dimerization of Water-Soluble Metalloporphyrins as Photosensitizers on the Efficiency of Generation of Singlet Oxygen. High Energy Chem. 2002, 36, 189–192. [Google Scholar] [CrossRef]
- Chen, Q.; Li, X.L.; Liu, Q.; Jiao, Q.C.; Cao, W.G.; Wan, H. Investigating the Binding Interaction of Azur A with Hyaluronic Acid via Spectrophotometry and Its Analytical Application. Anal. Bioanal. Chem. 2005, 382, 1513–1519. [Google Scholar] [CrossRef]
- Fagnola, M.; Pagani, M.P.; Maffioletti, S.; Tavazzi, S.; Papagni, A. Hyaluronic Acid in Hydrophilic Contact Lenses: Spectroscopic Investigation of the Content and Release in Solution. Contact Lens Anterior Eye 2009, 32, 108–112. [Google Scholar] [CrossRef]
- Amandusova, A.K.; Savelyeva, K.R.; Morozov, A.V.; Shelekhova, V.A.; Shestakov, V.N.; Persanova, L.V.; Polyakov, S.V. Physical and Chemical Properties and Quality Control Methods of Hyaluronic Acid (Review). Razrab. I Regist. Lek. Sredstv 2020, 9, 136–140. [Google Scholar] [CrossRef]
- Jiao, Q.; Liu, Q. Mechanism of Interference and Azur A Response in the Heparin Assay. Anal. Lett. 1998, 31, 1311–1323. [Google Scholar] [CrossRef]
- Liu, Q.; Jiao, Q.C.; Liu, Z.L.; Chen, H. The interaction of polysaccharides with a spectroscopic probe: The anion effect on the binding site of heparin. Spectrosc. Lett. 2001, 34, 25–34. [Google Scholar] [CrossRef]
- Jiao, Q.C.; Liu, Q.; Sun, C.; He, H. Investigation on the Binding Site in Heparin by Spectrophotometry. Talanta 1999, 48, 1095–1101. [Google Scholar] [CrossRef]
- Kardumyan, V.V.; Aksenova, N.A.; Chernyak, A.A.; Glagolev, N.N.; Volkov, V.I.; Solovieva, A.B. The Influence of Temperature on the Photo-Oxidation Rate of Tryptophan in the Presence of Complexes of Porphyrins with Amphiphilic Polymers. Laser Phys. 2015, 25, 046002. [Google Scholar] [CrossRef]
- Kuryanova, A.S.; Aksenova, N.A.; Savko, M.A.; Glagolev, N.N.; Dubovik, A.S.; Plashchina, I.G.; Timashev, P.S.; Solov’eva, A.B. Effect of Amphiphilic Polymers on the Activity of Rose Bengal during the Photooxidation of Tryptophan in an Aqueous Medium. Russ. J. Phys. Chem. 2022, 96, 1106–1111. [Google Scholar] [CrossRef]
- Wei, W.; Min, W.; Xuejun, K.; Ping, W.; Songqin, L. Spectrophotometry Study of Interaction of Hyaluronic Acid with Methylene Blue and Its Analytic Application. Anal. Lett. 2008, 41, 599–607. [Google Scholar] [CrossRef]
- Yazdani, O.; Irandoust, M.; Ghasemi, J.B.; Hooshmand, S. Thermodynamic Study of the Dimerization Equilibrium of Methylene Blue, Methylene Green and Thiazole Orange at Various Surfactant Concentrations and Different Ionic Strengths and in Mixed Solvents by Spectral Titration and Chemometric Analysis. Dye. Pigment. 2012, 92, 1031–1041. [Google Scholar] [CrossRef]
- Selvam, S.; Sarkar, I. Bile Salt Induced Solubilization of Methylene Blue: Study on Methylene Blue Fluorescence Properties and Molecular Mechanics Calculation. J. Pharm. Anal. 2017, 7, 71–75. [Google Scholar] [CrossRef]
- Mirzayeva, T.; Čopíková, J.; Kvasnička, F.; Bleha, R.; Synytsya, A. Screening of the Chemical Composition and Identification of Hyaluronic Acid in Food Supplements by Fractionation and Fourier-Transform Infrared Spectroscopy. Polymers 2021, 13, 4002. [Google Scholar] [CrossRef] [PubMed]
- Ovchinnikov, O.V.; Evtukhova, A.V.; Kondratenko, T.S.; Smirnov, M.S.; Khokhlov, V.Y.; Erina, O.V. Manifestation of Intermolecular Interactions in FTIR Spectra of Methylene Blue Molecules. Vib. Spectrosc. 2016, 86, 181–189. [Google Scholar] [CrossRef]
- De Oliveira, D.M.P.; Forde, B.M.; Kidd, T.J.; Harris, P.N.A.; Schembri, M.A.; Beatson, S.A.; Paterson, D.L.; Walker, M.J. Antimicrobial Resistance in ESKAPE Pathogens. Clin. Microbiol. Rev. 2020, 33, 10-1128. [Google Scholar] [CrossRef]
- Mulani, M.S.; Kamble, E.E.; Kumkar, S.N.; Tawre, M.S.; Pardesi, K.R. Emerging Strategies to Combat ESKAPE Pathogens in the Era of Antimicrobial Resistance: A Review. Front. Microbiol. 2019, 10, 539. [Google Scholar] [CrossRef]
- Urquhart, C.G.; Pinheiro, T.D.R.; Da Silva, J.L.G.; Leal, D.B.R.; Burgo, T.A.L.; Iglesias, B.A.; Santos, R.C.V. Antimicrobial Activity of Water-Soluble Tetra-Cationic Porphyrins on Pseudomonas aeruginosa. Photodiagnosis Photodyn. Ther. 2023, 42, 103266. [Google Scholar] [CrossRef]
- Hamblin, M.R. Antimicrobial Photodynamic Inactivation: A Bright New Technique to Kill Resistant Microbes. Curr. Opin. Microbiol. 2016, 33, 67–73. [Google Scholar] [CrossRef]
- Liu, Y.; Qin, R.; Zaat, S.A.; Breukink, E.; Heger, M. Antibacterial photodynamic therapy: Overview of a promising approach to fight antibiotic-resistant bacterial infections. J. Clin. Transl. Res. 2015, 1, 140. [Google Scholar]
- Zada, L.; Anwar, S.; Imtiaz, S.; Saleem, M.; Shah, A.A. In Vitro Study: Methylene Blue-Based Antibacterial Photodynamic Inactivation of Pseudomonas aeruginosa. Appl. Microbiol. Biotechnol. 2024, 108, 169. [Google Scholar] [CrossRef] [PubMed]
- Kuryanova, A.S.; Savko, M.A.; Kaplin, V.S.; Aksenova, N.A.; Timofeeva, V.A.; Chernyak, A.V.; Glagolev, N.N.; Timashev, P.S.; Solovieva, A.B. Effect of Chitosan and Amphiphilic Polymers on the Photosensitizing and Spectral Properties of Rose Bengal. Molecules 2022, 27, 6796. [Google Scholar] [CrossRef] [PubMed]

| [HA], wt. % | Slum 1276 nm,a.u. |
|---|---|
| 0 | 0.1879 ± 0.00245 |
| 0.0015 | 0.22185 ± 0.00165 |
| 0.0025 | 0.22185 ± 0.00715 |
| CMB | 2.5 × 10−6 M | 5 × 10−6 M | 1 × 10−5 M | |
|---|---|---|---|---|
| CHA | ||||
| 0 | 2.0 | 2.1 | 1.9 | |
| 0.0025% | 1.9 | 1.9 | 1.6 | |
| 0.0050% | 1.9 | 1.9 | 1.5 | |
| 0.0100% | 1.9 | 1.9 | 1.5 | |
| Sample | r of the Samples in Aqueous Solution (685 nm) |
|---|---|
| MB | 0.087 ± 0.003 |
| MB+HA (0.005%) | 0.095 ± 0.004 |
| MB+HA (0.010%) | 0.090 ± 0.007 |
| Position of Protons in the MB Molecule | MB Proton Signals, ppm | Position of Protons in the HA Molecule | HA Proton Signals, ppm | MB Proton Signals in the Presence of HA, ppm | HA Proton Signals in the Presence of MB, ppm |
|---|---|---|---|---|---|
| 1 | 7.14 7.24 | 3, 8 | 3.84 4.55 3.68 4.46 | 7.40 7.47 | - |
| 3 | 6.89 6.99 | 2–7, 9, 10 | 3.82 3.93 3.73 3.84 3.63 3.73 3.47 3.57 3.42 3.52 3.37 3.48 3.24 3.35 | 7.06 7.15 | 3.82 3.92 3.62 3.72 3.38 3.49 3.24 3.35 |
| 2 | 6.66 6.75 | 6.83 6.94 | |||
| 4 | 3.01 3.10 | 11 | 1.91 2.02 | 3.10 3.20 | 1.91 2.02 |
Disclaimer/Publisher’s Note: The statements, opinions and data contained in all publications are solely those of the individual author(s) and contributor(s) and not of MDPI and/or the editor(s). MDPI and/or the editor(s) disclaim responsibility for any injury to people or property resulting from any ideas, methods, instructions or products referred to in the content. |
© 2024 by the authors. Licensee MDPI, Basel, Switzerland. This article is an open access article distributed under the terms and conditions of the Creative Commons Attribution (CC BY) license (https://creativecommons.org/licenses/by/4.0/).
Share and Cite
Kardumyan, V.V.; Kuryanova, A.S.; Chernyak, A.V.; Aksenova, N.A.; Biryukov, M.V.; Glagolev, N.N.; Solovieva, A.B. Effect of Hyaluronic Acid on the Activity of Methylene Blue in Photogeneration of 1O2. Molecules 2024, 29, 5336. https://doi.org/10.3390/molecules29225336
Kardumyan VV, Kuryanova AS, Chernyak AV, Aksenova NA, Biryukov MV, Glagolev NN, Solovieva AB. Effect of Hyaluronic Acid on the Activity of Methylene Blue in Photogeneration of 1O2. Molecules. 2024; 29(22):5336. https://doi.org/10.3390/molecules29225336
Chicago/Turabian StyleKardumyan, Valeriya V., Anastasia S. Kuryanova, Aleksandr V. Chernyak, Nadezhda A. Aksenova, Mikhail V. Biryukov, Nicolay N. Glagolev, and Anna B. Solovieva. 2024. "Effect of Hyaluronic Acid on the Activity of Methylene Blue in Photogeneration of 1O2" Molecules 29, no. 22: 5336. https://doi.org/10.3390/molecules29225336
APA StyleKardumyan, V. V., Kuryanova, A. S., Chernyak, A. V., Aksenova, N. A., Biryukov, M. V., Glagolev, N. N., & Solovieva, A. B. (2024). Effect of Hyaluronic Acid on the Activity of Methylene Blue in Photogeneration of 1O2. Molecules, 29(22), 5336. https://doi.org/10.3390/molecules29225336

